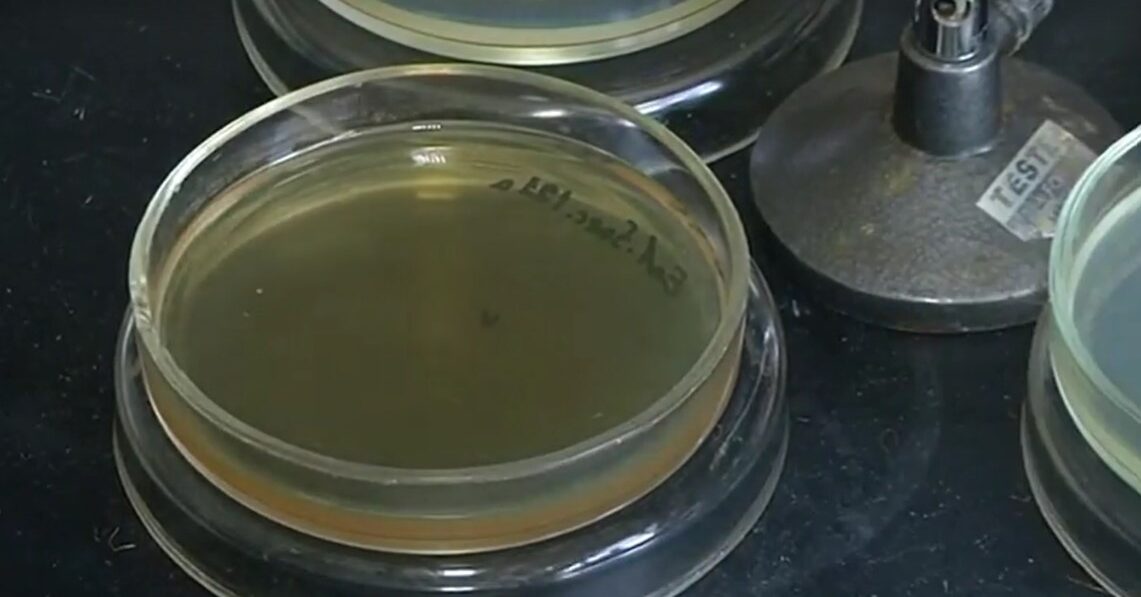

ลอนดอน 17 ก.ย.- ผลการศึกษาใหม่คาดการณ์ว่า วิกฤตเชื้อโรคที่ดื้อยาปฏิชีวนะ หรือที่เรียกว่าซูเปอร์บั๊ก (superbug) อาจทำให้ทั่วโลกมีผู้เสียชีวิตสะสมมากกว่า 39 ล้านคนตั้งแต่ขณะนี้ไปจนถึงในปี 2593
ผลการศึกษาที่เผยแพร่ในวารสารแลนเซ็ต (Lancet) ฉบับวันที่ 16 กันยายนคาดการณ์ว่า จำนวนผู้เสียชีวิตจากการติดเชื้อโรคที่ต้านทานต่อยาที่ใช้รักษาอาจเพิ่มขึ้นเกือบร้อยละ 70 ภายในปี 2593 การดื้อยาเกิดขึ้นเมื่อเชื้อโรคอย่างแบคทีเรียและเชื้อราพัฒนาตัวเองให้สามารถต้านทานยาที่เคยใช้ฆ่าเชื้อได้ องค์การอนามัยโลกระบุว่า ปัญหานี้เป็นหนึ่งในภัยคุกคามสาธารณสุขโลกอันดับต้น ๆ อันเป็นผลจากการใช้ยาต้านจุลชีพในคน สัตว์ และพืช อย่างไม่ถูกต้องและมากเกินไป
ผลการศึกษาชี้ว่า ภูมิภาคที่จะได้รับผลกระทบมากที่สุด ได้แก่ เอเชียใต้ ลาตินอเมริกาและแคริบเบียน และแอฟริกาที่อยู่ใต้ทะเลทรายซาฮารา เพราะส่วนใหญ่ขาดแคลนบริการสาธารณสุขที่มีคุณภาพ ดังนั้นหนทางที่จะลดยอดผู้เสียชีวิตจากซูเปอร์บั๊ก คือ การปรับปรุงการเข้าบริการสาธารณสุขที่มีคุณภาพ การพัฒนายาปฏิชีวนะที่มีประสิทธิภาพสูงยิ่งขึ้นและวิธีการต่าง ๆ ที่จะลดและรักษาการติดเชื้อ.-814.-สำนักข่าวไทย